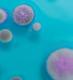
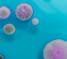

VAPORTEK

![]()

• Unik patenteret membran-teknologi.
• Neutraliserer lugte permanent med ren planteenergi.
• Biologisk nedbrydelig.
• Uskadelig for mennesker, dyr og materialer.
• Ozon- og aerosolfri metode, ingen sundhedsfare.
• Tilfører ikke fugt, som ved ULV-koldfoggere.
• Afdækning af løsøre/indbo ikke nødvendig.
• Evakuering/genhusning af personer ej nødvendig.
• Anvendelse: Akutte lugtskader, brand- og sodskader, vandskader, kloakskader, tørkogning, tørstegning, kemikaliespild, ligsanering, forrådnelse m.m.
• Ubegrænsede muligheder.
• Aktiv tørdamp behandler luft, løsøre og bygning samtidigt.
• Følg brugervejledningen. VAPORTEK
1. Den store etiketten plasseres på forsiden.





• Unik patenteret membran-teknologi.
• Neutraliserer lugte permanent med ren planteenergi.
• Biologisk nedbrydelig.
• Uskadelig for mennesker, dyr og
og bygning samtidigt. • Følg brugervejledningen.





1. Plasser den avlange etiketten bakerst til venstre.
2. "Fornøyde kunder" plasseres bakerst til høyre
3. Bruksanvisningen festes til håndtaket med en kabelstrips.

QR-koder plasseres til venstre. Adresseetikett plasseres til venstre. Fest plastlommen med A5-brosjyren fast på innsiden av lokket.



VaporSharkeneretenkelt,alsidigt,bærbart,elektriskapparatsomanvenderenuskadeligteknologi, somhurtigt,effektivtogpermanentfjernerildelugt ogfornyerluften indendørsrum.VaporSharken anvenderVaportekspatenteredemembransystem, somindeholderenkompleksblandingafover30 forskelligeog100%naturlige,æteriskeolier. Denbehandlerområderoptil2500m (800m pr. membranogenhedenerdesignettilatrummeop tiltremembraner)foreffektivtateliminerelugtforureninghurtigtogsikkert.Enhedenerprimært beregnettilatlevereenhurtiglugtneutraliserende behandling med høj intensitet. En karakteristisk neutraliserendeduftvilværeatmærkeunderdrift, datørdampafæteriskeoliercirkulerergennemhele behandlingsområdet.Resterendeduftforsvinder løbetaffåtimerefterbehandlingenerafsluttet. GENERELLEINSTRUKTIONER PlacérVaporSharkpåenfast,stabiloverfladepå etrelativthøjtsted.Kanbrugesfritståendeeller permanentinstalleret luftventilationssystemer. Førståbnesluftindtagetca.1,5cm.Efter10-15 minutterskalluftindtagetjusteresefterbehovfor entenatreduceretørdampfrigivelseellerøgetørdampfrigivelse(luk/åbenmere).NårVaporSharken ikkeer brug,læggesmembranerneidenlufttættepose,somplaceres dåsen(beggemedfølger). Lugtsaneringenkanklarespå15-60minutterved lettelugtgener.Vedmerealvorligelugtgenerkan behandlingentagefleretimerellerdage. FREMGANGSMÅDEVEDANVENDELSE AFVAPORSHARKEN: 1. Forudforanvendelsenerderforetageten genereloggrundigrengøringsamtfjernelseaf kildentillugtenf.eks.fjernelseafsodpartikler m.v.Vask/skyleventueltalleoverfladermed enaffølgendeVaportekECOZvådlugtsaneringskoncentrater:SOS(SmokeOdourSolution), ClassicNeutral,SummerOrangeellerLemon. VaporSharkenplaceresidetrum,somønskes lugtbehandlet.Placérapparatetsåhøjtsom





